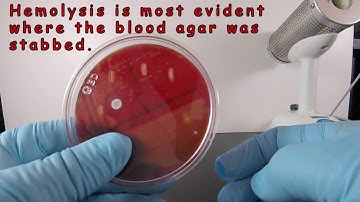
Beta Hemolysis on Blood Agar

⬇ DOWNLOAD NOW
Kalau muncul iklan pop-up, tutup lalu klik tombol kembali
Download lagu Streptococci Differentiation through use of Hemolysis and Lancefield secara gratis hanya untuk keperluan promosi. Dukung artis favorit kamu dengan membeli musik original di iTunes atau platform resmi lainnya.
 Microbiology - Streptococcus species
Microbiology - Streptococcus species
 Microbiology: Streptococcus & its Classification (Lancefield, Hemolytic) Detailed Lecture
Microbiology: Streptococcus & its Classification (Lancefield, Hemolytic) Detailed Lecture
 Streptococci | Introduction and Classification (Group A, Group B, Group D) | Microbiology 🧫
Streptococci | Introduction and Classification (Group A, Group B, Group D) | Microbiology 🧫
 Lancefield Groupings
Lancefield Groupings
 Microbiology: Hemolysis/Blood Agar
Microbiology: Hemolysis/Blood Agar
 Alpha Hemolysis and Identification of Streptococcus pneumoniae
Alpha Hemolysis and Identification of Streptococcus pneumoniae
Beta Hemolysis on Blood Agar
Beta Hemolysis on Blood Agar
 streptococci | Lancefield classification of streptococci | streptococcus species
streptococci | Lancefield classification of streptococci | streptococcus species